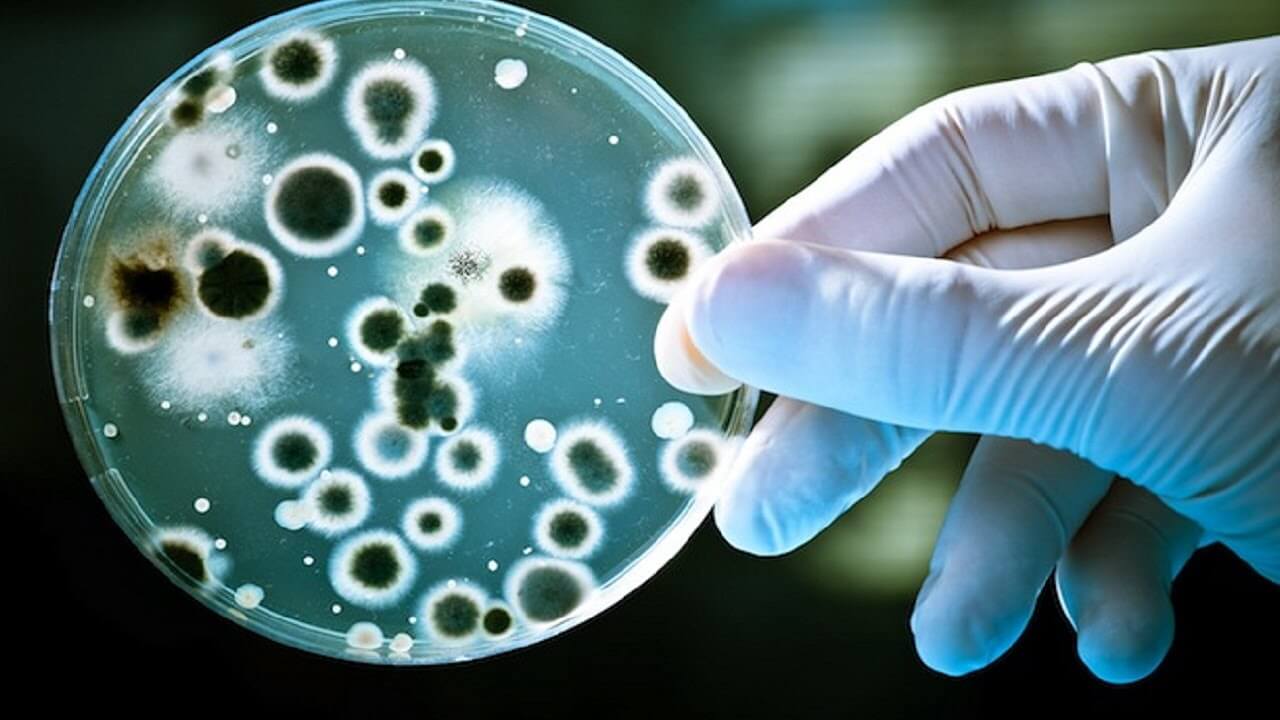
Оказалось, что некоторые бактерии прекрасно себя чувствуют на борту МКС. Фото.

Наверняка вы не раз обращали внимание на то, что ученые регулярно отправляют на борт Международной космической станции микроорганизмы для проведения исследований. Но что происходит с бактериями во время космических путешествий, мутируют ли они? Знание о том, как микробы ведут себя в непривычной для них среде обитания являются жизненно необходимыми для нас, если мы хотим колонизировать другие планеты. К тому же, мы стремительно приближаемся к отправке на Марс первых космонавтов, а в этом рискованном и опасном путешествии необходимо учесть множество переменных.
Оказалось, что некоторые бактерии прекрасно себя чувствуют на борту МКС
Стоит ли беспокоиться о мутантных бактериях в космосе?
Помните научно-фантастический роман Герберта Уэллса “Война миров”? В нем марсиане решили захватить нашу планету, однако в результате пали жертвой собственной непредусмотрительности — попав на Землю, инопланетные захватчики вступили в контакт с многочисленными микроорганизмами, обитающими на нашей планете. Именно они и принесли злобным марсианам погибель.

Кадр из фильма 2005 года “Война миров”
И действительно, роль микроорганизмов не стоит недооценивать. В конце-концов, каждый человек является носителем тысяч вирусов, бактерий и грибков: они составляют наш микробиом и сопровождают нас, куда бы мы ни отправились, даже в космос. Однако в космосе условия меняются, и необходимо знать, что именно происходит с микробами. Это особенно важно еще и потому, что мы говорим об организмах, способность к мутации у которых невероятно развита. Подумайте сами — бактерии обитают даже в самой негостеприимной среде на нашей планете.
Вам может быть интересно: Станут ли колонисты Марса мутантами?
Ряд исследований, проведенных с конца 2018 года, рисует не такую благоприятную картину, как хотелось бы будущим колонистам. Исследование, проведенное с несколькими штаммами бактерий Enterobacter, обнаруженными на МКС, выявило, что, несмотря на то, что эти бактерии не были патогенными, вероятность заболеть вследствие контакта с ними составляет 79%. А вот новая работа, опубликованная в журнале mSystems, описывает результат анализа, проведенного с бактериями, которые побывали на МКС. В данном случае речь идет о золотистом стафилококке (Staphylococcus aureus) и бацилле эхиноцереус (Bacillus cereus). Согласно полученным результатам, несмотря на экстремальные условия на МКС, бактерии мутируют и становятся «опасными». Более того, они приобретают устойчивость к антибиотикам.
Бактерии мутируют, чтобы выжить
Исследователи из Северо-Западного университета обнаружили, что, хотя изученные штаммы содержат генетический материал, отличный от и земных, эти гены не делают бактерии более опасными для человека. По мнению авторов исследования, бактерии реагируют и, возможно, эволюционируют для того, чтобы выжить в очень стрессовой среде.

Так золотистый стафилококк выглядит под микроскопом
В ходе проведения исследования, ученые использовали общедоступную базу данных, предоставленную Национальным центром биотехнологической информации США. В базе содержится геномный анализ многих бактерий, побывавших на МКС. Отметим, что выбранные виды бактерий обитают в разной среде: золотистый стафилококк живет на коже, а один из его штаммов, так называемый MRSA (устойчивый к метициллину), трудно поддается лечению. Бациллы эхиноцереус обитают в почве, а их деятельность оказывает небольшое влияние на здоровье человека.
Как думаете, безопасен ли окажется космический туризм? Давайте обсудим это с участниками нашего Telegram-чата.
По мнению ведущего автора исследования Эрика Хартманна, бактерии, которые живут на коже, отлично себя чувствуют на МКС. Дело в том, что кожа человека теплая и содержит органические и химические вещества, которые нравятся бактериям. Однако стоит удалить бактерии с кожи на МКС, как они моментально попадают в другую среду: холодную и агрессивную. И все же, гены бактерий помогают им выжить даже в таких суровых условиях. По мнению специалистов, подобная среда пробуждает “спящие” гены, которые дают бактериям преимущество и даже способствуют мутации. Как бы там ни было, цель у бактерий одна — выжить любой ценой.

А так под микроскопом выглядит Bacillus cereus
Несмотря на то, что это хорошие новости, специалисты очень осторожны в дальнейших прогнозах. Дело в том, что космонавты — это люди, обладающие отличным здоровьем. Однако когда в космос отправится большое количество туристов, здоровье которых не обязательно будет соответствовать здоровью космонавтов, неизвестно, что может произойти. Представьте, что произойдет, если поместить человека с инфекцией в закрытый пузырь в космосе? Это можно сравнить с человеком, который кашляет или чихает в самолете. А в этом случае, болезнь просто распространяется.



Новости, статьи и анонсы публикаций
Чат с читателямиСвободное общение и обсуждение материалов